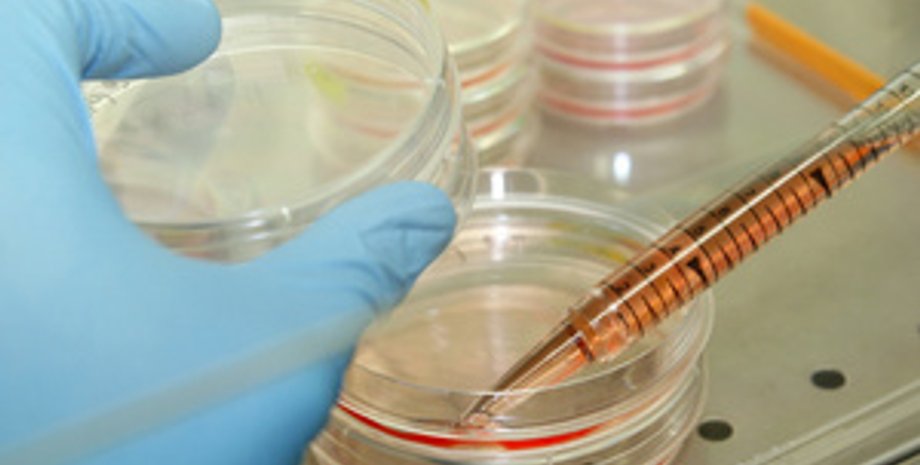

В США умер первый человек, заразившийся новым штаммом свиного гриппа
Официальные представители американского штата Огайо сообщили в пятницу о первом случае гибели человека, заразившегося новым штаммом свиного гриппа H3N2v, передает AP.
Как сообщило министерство здравоохранения штата, 61-летняя женщина, которая незадолго до того, как у нее появились симптомы свиного гриппа, контактировала со свиньями на одной из ярмарок, скончалась ранее на этой неделе. Вместе с тем, в сообщении указывается, что женщина также страдала от нескольких других заболеваний, которые вкупе с H3N2v могли привести к летальному исходу.
"Штамм H3N2v, как и другие вирусы, с большой долей вероятности поражает тех, у кого ослаблен иммунитет", - приводит телеканал WHIO-TV слова главы Минздрава Огайо Тэда Уаймисло (Ted Wymyslo), который также призвал людей, входящих в группу риска, не контактировать со свиньями и принимать все необходимые меры предосторожности.
AP отмечает, что федеральные власти выявили этим летом 288 случаев заражения людей штаммом H3N2v, из них 102 в Огайо.
Это позволяет говорить о перспективе создания универсального лекарства от этой болезни, говорится в статье, опубликованной в журнале Science.
По материалам РИА Новости
